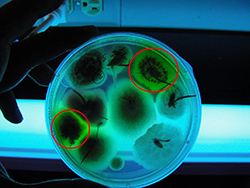

Septoria nodorum blotch a.k.a. Septoria glume blotch
Parastagonospora
nodorum (syn.
Stagonospora
nodorum); other synonyms encountered in literature are
Septoria
nodorum, Phaeosphaeria
nodorum, and
Leptosphaeria
nodorum.
Bread wheat
(Triticum
aestivum), durum wheat (Triticum
durum), and triticale are the major hosts.
Parastagonospora
nodorum,
Stagonospora
nodorum,
Septoria
nodorum, Phaeosphaeria
nodorum,
Leptosphaeria
nodorum, Stagonospora nodorum blotch, wheat foliar disease, glume blotch
Symptoms of Septoria nodorum blotch on wheat leaves. (Courtesy U. Adhikari)
Symptoms and Signs
Symptoms
Parastagonospora
nodorum, the causal agent of Septoria nodorum blotch (SNB), produces symptoms on all aboveground parts of the plant; i.e. leaves, leaf sheaths, stems, glumes, and awns (Figures 1,
2, and
3). On leaves, initial symptoms of SNB appear as small dark-brown to chocolate-colored lesions, usually on the mid-rib of older leaves that are close to the soil surface. These lesions typically have a yellow halo (Figure 1) as a result of diffusible toxins produced by the pathogen. The lesions expand and become oval (lens-shaped) or elliptical with dark-brown centers. A mature SNB lesion has a grayish-white center with a dark-brown periphery. In severe epidemics, lesions can coalesce to cover the whole leaf, resulting in the death of the leaf tissue. On the glumes and awns, symptoms appear as tan to brown-colored lesions (Figure 2). The lesion on a glume typically starts at the tip of the glume and progresses downward. The pathogen can also produce dark-brown lesions on stems and nodes (hence the species name "nodorum") of wheat plant. Infected glumes lead to shriveled kernels that reduce grain quality and quantity (Figure 4).
 Figure 1. A typical elliptical lesion of Septoria nodorum blotch. Notice the prominent chlorotic (yellow) halo. (Courtesy U. Adhikari). |
 Figure 2. Brown to tan colored lesions of Septoria nodorum blotch on wheat glumes. (Courtesy R. Weisz). |
Figure 3. Wheat experimental plots showing heavy glume infection (brown to tan colored discoloration of heads). (Courtesy L. Mehra).
|
Figure 4. Shriveled wheat kernels (right) in comparison to healthy kernels (left). Shriveled kernels were harvested from a wheat plot with infection of Parastagonospora nodorum. (Courtesy: U. Adhikari)
|
Signs
As the diagnostic oval-shaped lesions expand and become necrotic, the center of the lesion turns light-brown in color and, at the center, small pin-head sized black structures can be seen, arranged in an irregular pattern. Those structures are flask-shaped asexual fruiting structures of the fungus (also known as pycnidia, sing. pycnidium) (Figures 5,
6, and
7). Pycnidia contain diagnostic asexual spores known as conidia (sing. conidium; or pycnidiospores) in a mucilaginous mass (Figures 8 and 9). White to pinkish masses of conidia (cirrhi, sing. cirrhus) exude from pycnidia after placing SNB- infected leaf tissue on moist paper for three to seven days. These asexual fruiting structures are produced on glumes and stems. At the end of the season, another type of fruiting body is formed on plant debris. These structures, known as pseudothecia (sing. pseudothecium), are also flask-shaped, but in contrast to pycnidia are sexual structures of the fungus that contain ascospores (sexual spores) in asci (sac-like structures holding ascospores, usually eight per ascus). A hand lens (20× mag.) may be needed to clearly see these structures in the field, while more details can be seen under dissecting and compound microscopes (Figures 6 and
7).

Figure 5. Pycnidia (pin-head sized black structures) of Parastagonospora nodorum are visible within in the lesion. Red arrows point to some of the pycnidia. Image taken from the eyepiece of the dissecting scope (12x magnification) using smartphone camera (Courtesy: U. Adhikari).
| 
Figure 6. Pycnidia of Parastagonospora nodorum on wheat leaf tissue, five days after incubation on moist filter paper. In some pycnidia (see red arrows), circular opening (ostiolum) is also visible. (Courtesy: U. Adhikari).
| 
Figure 7. Pycnidia of Parastagonospora nodorum on wheat straw, seven days after incubation on water agar. Red arrows point to some of the pycnidia (Courtesy: U. Adhikari).
|

Figure 8. Seven-day-old colony of Parastagonospora nodorum on V-8 agar medium in 9-cm diameter Petri dish. (Courtesy: U. Adhikari).
| 
Figure 9. Conidia released from pycnidium of Parastagonospora nodorum; magnified at 400× (indicated by red arrow). Inset shows mucilaginous masses (cirrhi) oozing out of pycnidia (asexual fruiting bodies) that are formed on artificial growth medium (V8-agar medium); magnified at 54× (Courtesy: U. Adhikari).
| 
Figure 10. Conidia of Parastagonospora nodorum. White arrows indicate three septa of a conidium; magnified at 1000× (Courtesy: U. Adhikari).
|
Pathogen biology
Asexual reproduction
Parastagonospora
nodorum is a necrotrophic fungus (a fungus that feeds on dead plant tissue) that belongs to phylum Ascomycota of kingdom Fungi. Conidia of the fungus are hyaline and slender, measuring 15 to 24 µm in length and 2.5 to 4.0 µm in width and have three (and occasionally one or two) conspicuous septa (Figure 10). A leaf wetness duration of 8 to 12 hours is required for pycnidia to release conidia. The majority of conidia are released during the first wetting of pycnidia. It is estimated that on average there are 3 million conidia available per 10 cm2 of leaf to cause infection. This high conidial production ensures that at least some conidia can land on upper leaves with the help of rain-splash and cause disease. The pathogen is able to penetrate the leaf cuticle directly. Pycnidia form on the plant within 7 to 14 days after inoculation under optimum conditions of temperature and moisture. Such a short incubation period can result in multiple infection cycles per season, giving rise to a significant amount of secondary inoculum. The conidium germinates to produce a penetration peg, which releases enzymes to help in direct penetration of the wheat leaf cuticle. Colonization and necrosis (brown discoloration) of the host tissue follows direct penetration.
Sexual reproduction
The ascospores produced in sac-like asci in pseudothecia are 4 celled and slightly curved. Ascospores are hyaline to yellow in color, and measure 4 to 6 µm in width and 19 to 32 µm in length (https://www.ncbi.nlm.nih.gov/pmc/articles/PMC3713890/figure/F59/; in Quaedvlieg et al. 2013). The formation of pseudothecia requires the presence of two opposite mating types (heterothallic fungus). Sexual reproduction is important in introducing genetic variation into the pathogen population. Pseudothecia take approximately twice as long to develop than pycnidia, which is why they are more commonly found on wheat stubble than leaves.
Necrotrophic effectors (host-selective toxins)
In addition to being an important pathogen of wheat,
P. nodorum also serves as a model organism for necrotrophic fungal pathogens; its genome was published in 2007. It secretes various host-selective toxins (more recently termed “necrotrophic effectors") to kill host tissue during colonization. Necrotrophic effectors (NE) of
P.
nodorum interact with corresponding sensitivity genes in wheat in an “inverse gene-for-gene" manner. Recognition of a specific NE by the corresponding dominant sensitivity (Snn) gene in wheat may enhance host susceptibility. Thus far, nine such NE-host sensitivity gene interactions have been identified: SnToxA-Tsn1, SnTox1-Snn1, SnTox2-Snn2, SnTox3-Snn-B1, SnTox3-Snn3-D1, SnTox4-Snn4, SnTox5-Snn5, SnTox6-Snn6, and SnTox7-Snn7, as described in Peters Haugrud et al. 2019. These interactions occur under field conditions as well. However, in the overall disease process, the relative importance of Snn-NE interactions as compared to other genes in the host and pathogen is still not well understood, and appears to depend on which Snn-NE pair is present, as well as other factors.
Disease cycle and epidemiology
Disease cycle
The pathogen overwinters on wheat residue in the form of pseudothecia and pycnidia. Ascospores released from pseudothecia are usually the source of primary inoculum; however, conidia splashed from wheat debris to the young seedlings can also initiate the disease. The fungus is also known to survive on seed as dormant mycelium and colonized seed can be a source of primary infection. Mature lesions on plant leaves contain pinhead-sized pycnidia that are the source of secondary inoculum. The secondary spread of the pathogen within the season occurs when rain-splashed conidia are spread from lower leaves to upper leaves and to glumes. This pathogen also produces multiple host selective toxins that aid in infection by killing the cells before hyphal colonization. Susceptibility in the host is influenced by the interaction between necrotrophic effectors produced by the pathogen and sensitivity genes present in the host, and likely by other interacting gene products as well. Infected wheat residue left in the field and infected grain (if used for seed) serve as the source of inoculum in the following year, and the disease cycle continues (Figure 11).
|
Figure 11. Disease cycle of Septoria nodorum blotch, caused by Parastagonospora nodorum (modified from Brodal et al. 2009; original drawing by H. Karlsen). Overwintering: the pathogen overwinters in wheat debris in the form of pseudothecia and/or pycnidia; Primary infection: The primary inoculum can be in the form of windborne ascospores released from pseudothecia or from splash-dispersed conidia released from pycnidia; Secondary spread: vertical spread of the pathogen occurs with splash dispersal of conidia from lower canopy to upper, and to glumes eventually, and Seedborne infection: if infected seed is used for planting the following season, seedling infection can occur from the dormant mycelium in the seed.
|
Epidemiology
Primary inoculum in the field can be infected seed (harboring mycelia of the fungus), rain-splashed conidia or windborne ascospores from infected wheat debris. Release of ascospores from pseudothecia is highly dependent on weather variables [rainfall >1 mm, temperature above 0°C, and high (75–95%) relative humidity]. Initial infection is not solely dependent on immigrant ascospores but can also be caused by seedborne inoculum (Bergstrom 2010). Transmission of the pathogen from seed to coleoptile and the first leaf decreases with increase in temperature. It is likely that seed infection plays a relatively bigger role in regions where mean temperature is lower (around 9°C). Severity of Septoria nodorum blotch is known to increase with increasing amounts of wheat residue on the ground.
Disease symptoms appear first on the oldest leaves in early spring. Lesions can expand and coalesce, leading to necrosis of the entire leaf. Small (160–210 µm in diameter) fruiting bodies (pycnidia) are formed within mature lesions one to two weeks after infection under high relative humidity (Figures 5 and
6). Both conidia and ascospores can germinate and cause infection between 5 and 35°C (optimum 15 to 25°C), and penetration occurs directly through the cuticle or opportunistically through stomata. The optimum temperature for the development of disease symptoms and pycnidia formation is 20°C.
The rate at which an epidemic spreads is dependent upon the latent period, which is defined as the period between inoculation of host tissue and sporulation. The latent period of
P. nodorum varies greatly – from 6 to 49 days across various studies – and is dependent on temperature, moisture, and cultivar. Septoria nodorum blotch development is also favored by rainstorms, which can cause sudden outbreaks and fast vertical spread from lower leaves to upper leaves.
Prediction models for SNB
Several prediction models have been developed to predict epidemics of SNB. Tyldesley and Thompson (1980) developed a model that had 71% accuracy in predicting SNB epidemics based on the frequency of rainfall in England and Wales. Similar qualitative thresholds were provided in Denmark (Hansen et al. 1994) for both Septoria nodorum blotch and Septoria tritici blotch, where eight days with rainfall ≥1 mm in a 30-day period starting at stem elongation correlated with disease severity and yield response. An expert system called EPINFORM was developed in Montana to provide estimates of damage caused by SNB and stripe rust (Puccinia
striiformis). Their system relied upon the number of infection cycles necessary to cause yield penalty; however, it was assumed that inoculum is present in the field at all times and weather is the only deciding factor in initiating the infection cycle. In general, these modelling efforts have found rainfall to be a significant predictor of end-of-season SNB intensity.
More recently, a risk assessment model was developed to select cultivars at the beginning of the season based on the location of the field and residue management practices adopted by the grower. It has also been confirmed that early onset of disease results in increased yield losses, and disease onset can be predicted based on weather variables and pre-planting factors such as amount of wheat residue and location of the field. More research is needed to validate these models and deploy them for public use.
Disease management
Cultural management
Septoria nodorum blotch can be managed by using a variety of cultural practices that include crop rotation and tillage that ensures complete burial of residue. While crop rotation and tillage have been shown to reduce end-of-season severity of SNB, their effectiveness depends on their widespread adoption, because aerial ascospores from adjacent fields may lead to disease development in fields without wheat residue on the soil surface. Removal of wild grasses that can act as alternative host may aid in reducing disease spread.
Chemical management
Since one of the sources of inoculum for this pathogen is infected seed, proper seed treatment with a fungicide is recommended to reduce this source of primary inoculum. Infected seed has the potential to start epidemics at multiple foci in a disease-free field. Seeds can be tested for the presence of the pathogen by plating them on the selective medium SNAW (S. nodorum agar for wheat). If mycelium of P. nodorum is present, it fluoresces under near ultraviolet light and also sporulates within 7 days (Figure 12). Foliar fungicide sprays are effective in controlling SNB, and the recommended ones are triazoles (e.g. metaconazole and prothioconazole); site-specific fungicides such as strobilurins (e.g. pyraclostrobin, azoxystrobin, and picoxystrobin); and combinations of strobilurins and triazoles (e.g. trifloxystrobin + prothioconazole). The goal of fungicide application should be to protect the flag leaf and F-1 (the leaf below flag leaf) because these leaves provide the majority of photosynthates to the developing spike.
|
Figure 12. Seed infected with Parastagonospora nodorum fluorescing under near-ultraviolet light when grown on a selective medium for the pathogen (Courtesy L. Mehra).
|
Host resistance
Winter wheat cultivars with partial resistance to SNB are available, and breeding efforts are underway at several universities to develop SNB-resistant varieties. Breeders are mapping populations to find quantitative trait loci (QTL) associated with SNB resistance in wheat and facilitating marker-assisted selection. Advanced experimental lines from central and eastern U.S. breeding programs are screened each year for SNB resistance in irrigated, inoculated nurseries (USDA-ARS Eastern Stagonospora Nursery).The most recent data on SNB resistance in the USA can be found in the USDA-ARS Eastern Stagonospora nursery reports (https://www.ars.usda.gov/southeast-area/raleigh-nc/plant-science-research/docs/nursery-reports/page-6/). If available, the use of resistant cultivars in managing SNB is recommended (Figure 13). While resistance in wheat to P. nodorum is quantitative or partial in nature, moderate resistance is usually sufficient by itself for SNB management, at least under eastern US conditions.
|
Figure 13. SNB susceptibility (left) compared to moderate resistance (right) in advanced experimental winter wheat lines screened in an inoculated, irrigated USDA-ARS SNB nursery. Piedmont Research Station, North Carolina, 2009 (Courtesy: C. Cowger).
|
Significance
Septoria nodorum blotch occurs in wheat-growing areas worldwide, but the disease is more prevalent in areas with warm and moist weather, such as the southeastern United States, parts of Europe, southern Brazil, and Australia. The disease affects both the quantity and quality of yield, and the pathogen is capable of affecting wheat at both seedling and adult stages. Historically, losses up to 50% have been reported, in addition to lower grain quality, although in the U.S., lower levels of loss are typical. The yield losses are highest when flag leaf, F-1 (leaf below flag leaf), and F-2 (leaf below F-1) are infected. The disease is known to reduce thousand-kernel-weight, a yield parameter.
The fungus undergoes regular cycles of sexual recombination due to the availability of both mating types, and creates genetic variation in its population, thus enhancing its potential to overcome control measures. The pathosystem is also a model system for necrotrophic plant pathogens. So far, nine necrotrophic effectors and host susceptibility gene interaction have been identified, which have the potential to be used in marker assisted selection for breeding resistant wheat varieties.
Selected References:
Bergstrom, G. C. 2010. Stagonospora nodorum blotch and Stagonospora avenae blotch. Pages 75–77 in: Compendium of Wheat Diseases, 3rd ed. R. W. Bockus, W.W. Bowden, R. L. Hunger, R. M. Morrill, W. L. Murray, and T. D. Smiley, eds. APS Press, St. Paul, MN.
Brodal, G., Henriksen, B., and Sundhein, L. 2009. Diseases of cereals, oil seed crops and field legumes. Pages 107-141 in: Bioforsk Focus vol. 4 no. 4. Plantevern og plantehelse i økologisk landbruk. Bind 3 – Korn, oljevekster og kjernebelgvekster. L. O. Brandsæter, K. Mangerud, S. M. Birkenes, G. Brodal, and A. Andersen, eds. Bioforsk, Ås, Norway.
Cowger, C., and Silva-Rojas, H. V. 2006. Frequency of Phaeosphaeria nodorum, the sexual stage of Stagonospora nodorum, on winter wheat in North Carolina. Phytopathology 96:860–866.
Eyal, Z., Scharen, A. L., Prescott, J. M., and Van Ginkel, M. 1987. The Septoria diseases of wheat: concepts and methods of disease management. CIMMYT, Mexico, DF, Mexico.
Ficke, A., Cowger, C., Bergstrom, G., and Brodal, G. 2018. Understanding yield loss and pathogen biology to improve disease management: Septoria nodorum blotch - A case study in wheat. Plant Dis. 102:696–707.
Hansen, J. G., Secher, B. J. M., Jørgensen, L. N., and Welling, B. 1994. Thresholds for control of
Septoria spp. in winter wheat based on precipitation and growth stage. Plant Pathol. 43:183–189.
Leath, S., Scharen, A. L., Lund, R. E., and Dietz-Holmes, M. E. 1993. Factors associated with global occurrences of Septoria nodorum blotch and Septoria tritici blotch of wheat. Plant Dis. 77:1266–1270.
Mehra, L. K., Cowger, C., Gross, K., and Ojiambo, P. S. 2016. Predicting pre-planting risk of Stagonospora nodorum blotch in winter wheat using machine learning models. Front. Plant Sci. 7:390.
Mehra, L. K., Cowger, C. and Ojiambo, P. S. 2017. A model for predicting onset of Stagonospora nodorum Blotch in winter wheat based on preplanting and weather factors. Phytopathology 107:635–644.
Mehra, L. K., Cowger, C., Weisz, R., and Ojiambo, P. S. 2015. Quantifying the effects of wheat residue on severity of Stagonospora nodorum blotch and yield in winter wheat. Phytopathology 105:1417–1426.Peters Haugrud, A. R., Zhang, Z., Richards, J. K., Friesen, T. L., and Faris, J. D. Genetics of variable disease expression conferred by Inverse Gene-For-Gene interactions in the Wheat-Parastagonospora nodorum pathosystem. Plant Physiol. 180:420–434.
Quaedvlieg, W., Verkley, G. J. M., Shin, H.-D., Barreto, R. W., Alfenas, C., Swart, W. J., Groenewald, J. Z., and Crous, P. W. 2013. Sizing up
Septoria. Stud. Mycol. 75:307–390.
Tyldesley, J. B., and Thompson, N. 1980. Forecasting Septoria nodorum on winter wheat in England and Wales. Plant Pathol. 29:9-20.
Solomon, P. S., Lowe, R. G. T., Tan, K. C., Water, O. D. C., and Oliver, R. P. 2006. Stagonospora nodorum; cause of Stagonospora nodorum blotch of wheat. Mol. Plant Pathol. 7:147–156.
USDA-ARS Eastern Stagonospora Nursery, https://www.ars.usda.gov/southeast-area/raleigh-nc/plant-science-research/docs/nursery-reports/page-6/